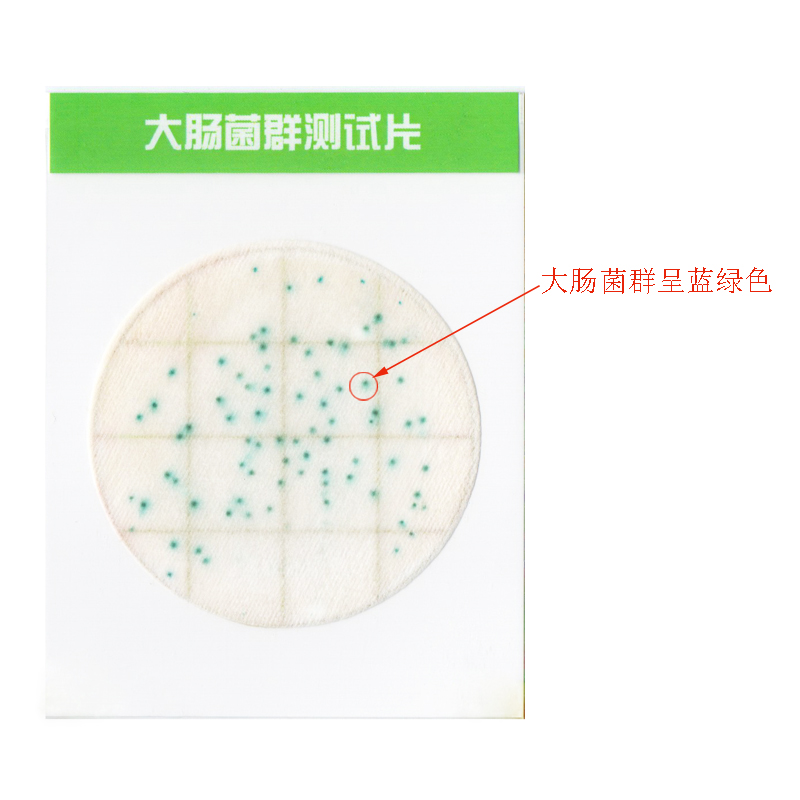
大腸菌群陽(yáng)性.jpg

大腸菌群測(cè)試片(Ⅱ代)
適合于食品、飲用水及原料中大腸菌群的計(jì)數(shù)。執(zhí)行標(biāo)準(zhǔn):食品安全國(guó)家標(biāo)準(zhǔn) 食品微生物學(xué)檢驗(yàn) 大腸菌群計(jì)數(shù)(GB 4789.3)
產(chǎn)品參數(shù):
詳細(xì)介紹:
1 原理及適用范圍
大腸菌群是評(píng)價(jià)食品衛(wèi)生質(zhì)量的重要指標(biāo)之一,目前已被廣泛應(yīng)用于食品衛(wèi)生檢驗(yàn)工作中。大腸菌群多存在于溫血?jiǎng)游锛S便、人類(lèi)經(jīng)常活動(dòng)的場(chǎng)所以及有糞便污染的地方,大腸菌群數(shù)的高低,表明了食品及食品生產(chǎn)過(guò)程中受污染的程度。大腸菌群測(cè)試片含有選擇性培養(yǎng)基、大腸菌群特異性半乳糖苷酶的顯色指示劑和高分子吸水凝膠,運(yùn)用微生物測(cè)試片專(zhuān)有技術(shù),做成一次性快速檢驗(yàn)產(chǎn)品。本產(chǎn)品適合于食品、飲用水及原料中大腸菌群的計(jì)數(shù)。執(zhí)行標(biāo)準(zhǔn):食品安全國(guó)家標(biāo)準(zhǔn) 食品微生物學(xué)檢驗(yàn) 大腸菌群計(jì)數(shù)(GB 4789.3)。
2 操作方法
2.1 樣品處理:取樣品 25 mL(g)放入含有225 mL滅菌磷酸緩沖液稀釋液(或生理鹽水)的取樣罐或均質(zhì)杯內(nèi),制成1:10的樣品勻液,用1mL滅菌吸管吸取1:10樣品勻液1mL,注入含有9mL稀釋液的試管內(nèi),振搖后成為1:100的樣品勻液, 以此類(lèi)推,每次換一支吸管。
2.2 接種:一般食品選2~3個(gè)適宜的稀釋度進(jìn)行檢測(cè),含菌量少的液體樣品(如飲用純水和礦泉水等)可直接吸取原液進(jìn)行檢測(cè)。將大腸菌群測(cè)試片置于平坦實(shí)驗(yàn)臺(tái)面,翻開(kāi)測(cè)試片蓋膜,用無(wú)菌吸管吸取1mL樣品勻液均勻地滴加到紙片上,等待紙片完全吸收液體,慢慢放下蓋膜,每個(gè)稀釋度接種兩片。同時(shí)做一片空白陰性對(duì)照。
2.3 培養(yǎng):將測(cè)試片疊在一起水平置于恒溫培養(yǎng)箱內(nèi),堆疊片數(shù)不超過(guò)10片。培養(yǎng)溫度為36℃±1℃,培養(yǎng)15~24h。
3 計(jì)數(shù)原則及報(bào)告方式:
3.1 培養(yǎng)后紙片上的藍(lán)色菌落為大腸菌群菌落,選擇菌落數(shù)在15 CFU~150 CFU之間的紙片進(jìn)行計(jì)數(shù)。
3.2 若兩個(gè)稀釋度的菌落數(shù)均在15 CFU~150 CFU之間,則取其平均菌落數(shù)乘以稀釋倍數(shù)報(bào)告之,即為每毫升(或每克)樣品中的大腸菌群菌落數(shù);
3.3 如果所有稀釋度的測(cè)試片上的菌落數(shù)都小于15 CFU,則計(jì)數(shù)稀釋度最低的測(cè)試片上的平均菌落數(shù)乘以稀釋倍數(shù)報(bào)告之;
3.4 如果所有稀釋度的測(cè)試片上均無(wú)菌落生長(zhǎng),則以小于1乘以最低稀釋倍數(shù)報(bào)告之;
3.5 如果最高稀釋度的測(cè)試片上的菌落數(shù)大于150 CFU個(gè)時(shí),計(jì)數(shù)最高稀釋度的測(cè)試片上的平均菌落數(shù)乘以稀釋倍數(shù)報(bào)告之。報(bào)告單位以CFU/mL(或CFU/g)表示。
4 附加說(shuō)明
4.1 大腸菌群測(cè)試片不但可以大大縮短檢測(cè)時(shí)間,而且檢測(cè)結(jié)果與傳統(tǒng)方法很接近,符合率可達(dá)90%左右。